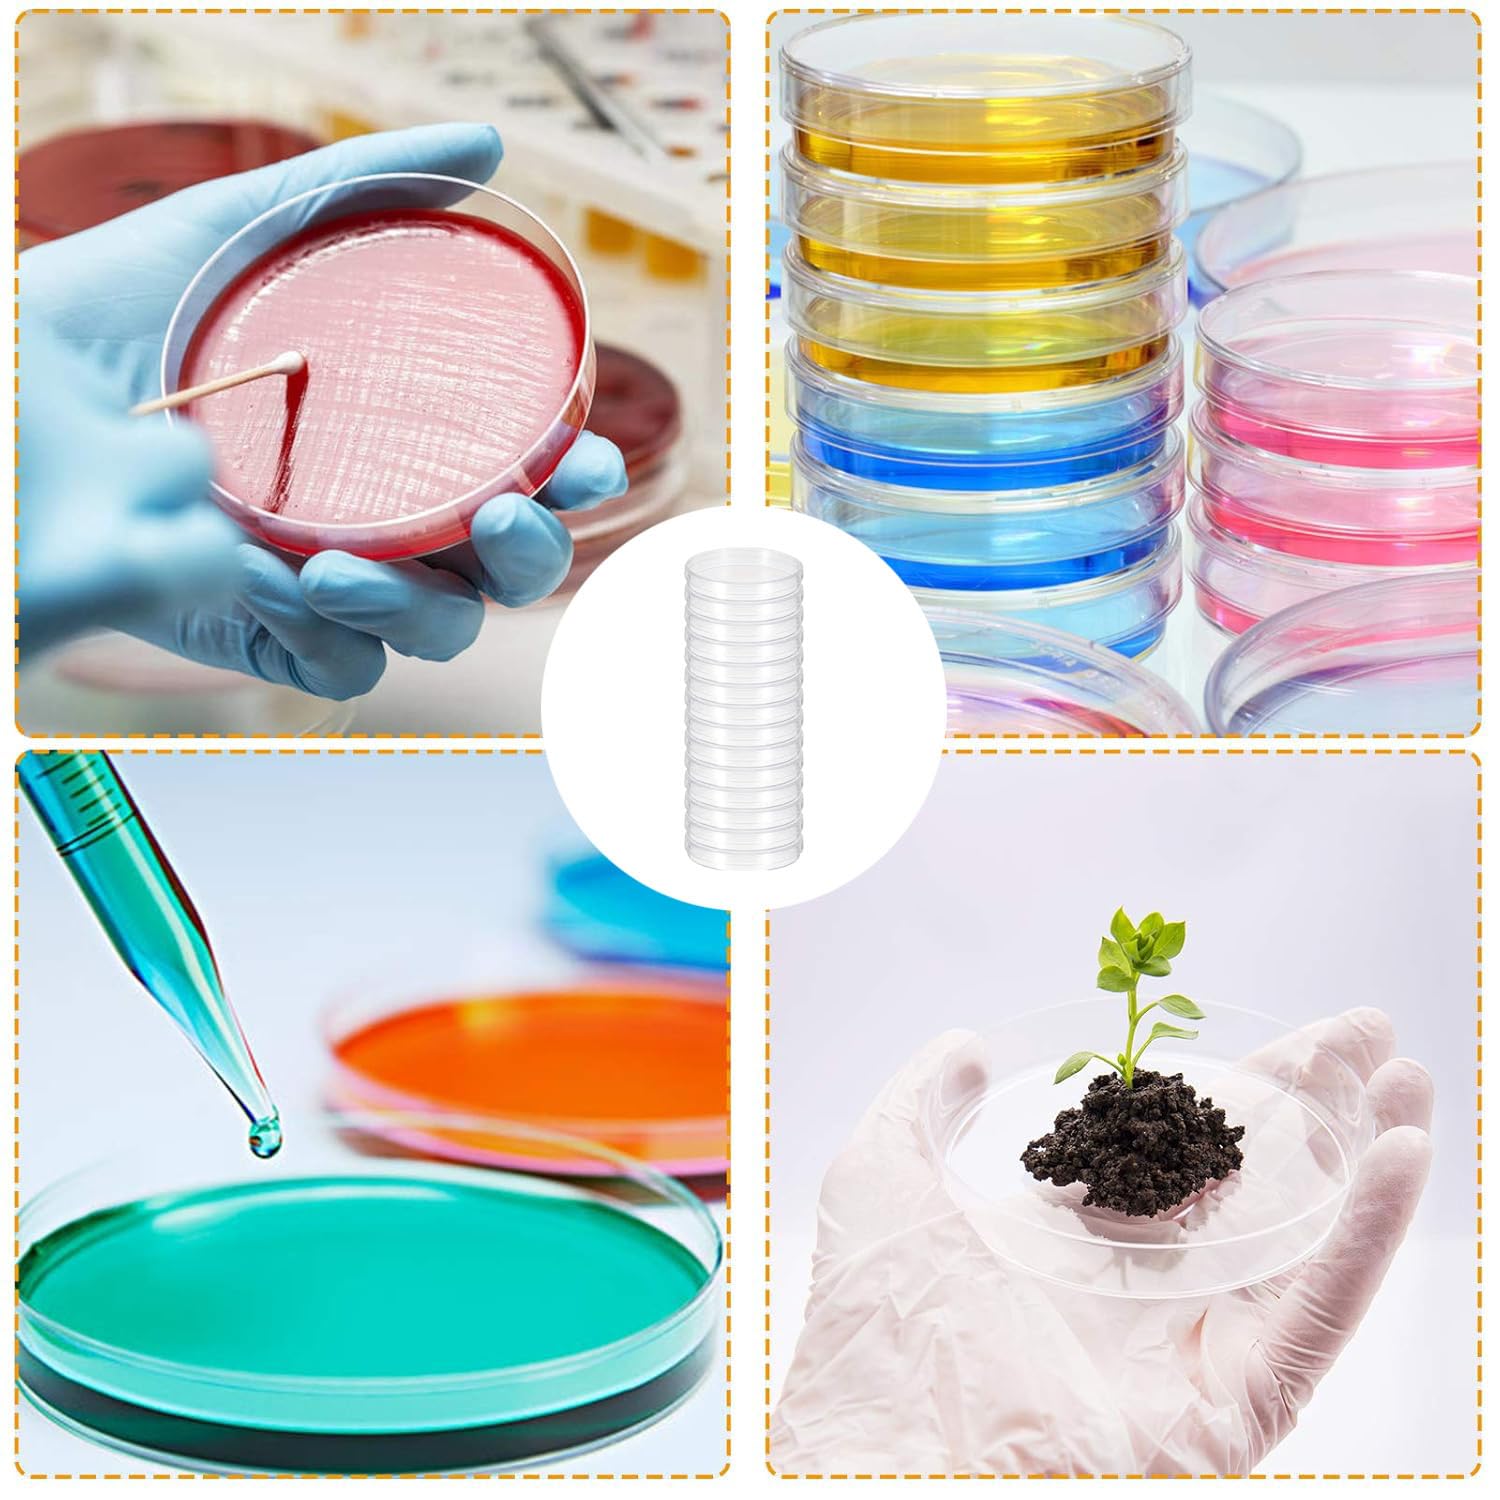
Set 30 Ciotole Di Petri Sterili - 35 Mm Per Colture Batteriche - Foto 8

Set 30 Ciotole Di Petri Sterili - 35 Mm Per Colture Batteriche
Disponibile
Disponibile
€ 4
AGGIUNGI AL CARRELLO
Consegna
- Corriere espressoda domenica 1 marzoGRATIS
Venduto e spedito da ePRICE

Altri 22 venditori a partire da € 5
- Informazioni legali
- Ne hai uno da vendere?
- 1224723
- 56596998699
Pensati per Te
Prodotti simili
Descrizione
Sei un appassionato di scienza o lavori in laboratorio? Questo set di 30 ciotole di Petri da 35 mm è sterile e pronto all'uso. Realizzato in plastica trasparente di alta qualità, permette una visione chiara al microscopio. Ideale per colture batteriche, lieviti o esperimenti microbiologici. Il coperchio si adatta perfettamente per evitare contaminazioni. Confezione include anche contagocce per precisione. Perfetto per scuole, università o hobby scientifici. Sperimenta in totale sicurezza e professionalità. Un must per ogni laboratorio!Caratteristiche e scheda tecnica
Caratteristiche principali
- EAN1184486112224
Recensioni
2026-02-22 | u3nuhxj